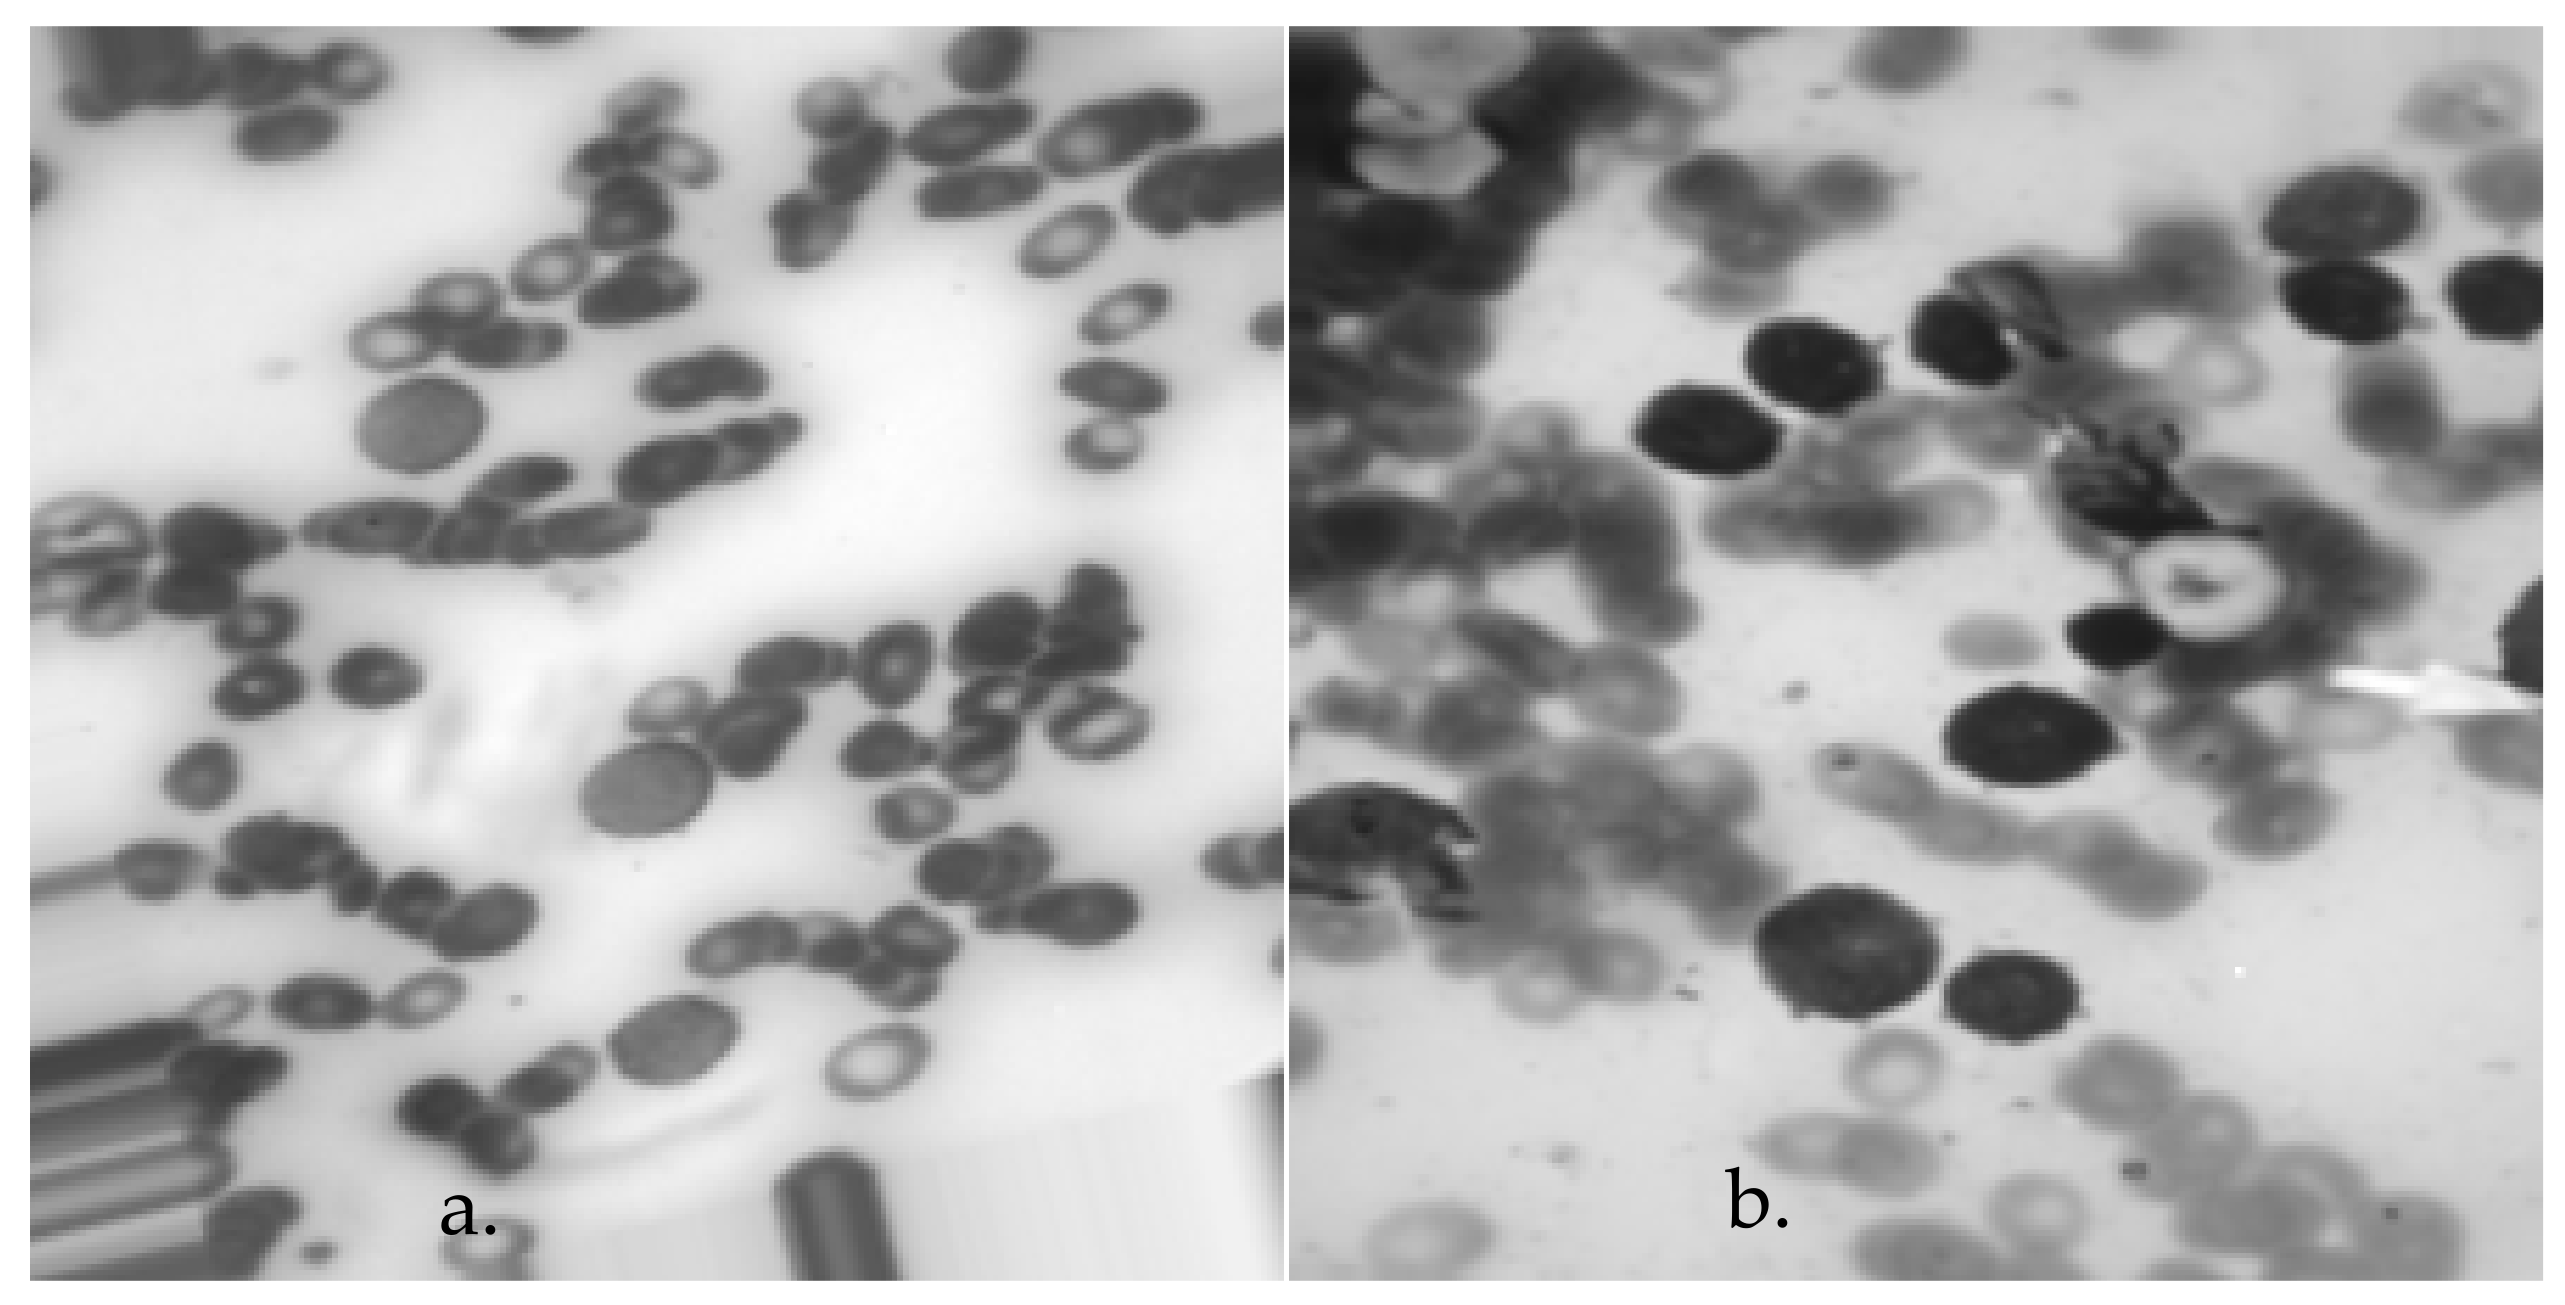
Bioengineering 11 00644 g004

Automatic Detection of Acute Leukemia (ALL and AML) Utilizing Customized Deep Graph Convolutional Neural Networks
Abstract
1. Introduction
- Providing a standard database based on two classes, ALL and AML.
- Presenting an automatic (end-to-end) model for diagnosing acute leukemia using graph theory and deep convolutional networks.
- Providing the highest level of accuracy when classifying two groups, ALL and AML.
2. Materials and Methods
2.1. General Model of Generative Adversarial Networks
2.2. General Model of Graph Convolutional Network
3. Proposed Model
3.1. Data Collection
3.2. Pre-Processing
3.3. Graph Design
3.4. Architecture
3.5. Training, Validation, and Test Series
4. Results
4.1. Optimization Results
4.2. Simulation Results
5. Discussion
6. Conclusions
Author Contributions
Funding
Institutional Review Board Statement
Informed Consent Statement
Data Availability Statement
Conflicts of Interest
References
- McKeague, S.J.; O’Rourke, K.; Fanning, S.; Joy, C.; Throp, D.; Adams, R.; Harvey, Y.; Keng, T.B. Acute leukemia with cytogenetically cryptic FGFR1 rearrangement and lineage switch during therapy: A case report and literature review. Am. J. Clin. Pathol. 2024, 161, 197–205. [Google Scholar] [CrossRef] [PubMed]
- Pelcovits, A.; Niroula, R. Acute myeloid leukemia: A review. Rhode Isl. Med. J. 2020, 103, 38–40. [Google Scholar]
- Fathi, M.; Moghaddam, N.M.; Jahromi, S.N. A prognostic model for 1-month mortality in the postoperative intensive care unit. Surg. Today 2022, 52, 795–803. [Google Scholar] [CrossRef] [PubMed]
- Luo, L.; Wang, X.; Luo, J.; Zheng, S.; Gong, N.; He, Y.; Xi, Q.; Chen, J.; Jiang, T.; Zhong, L. Acute undifferentiated leukemia with undifferentiated myeloid sarcoma: Case report and literature review. Medicine 2024, 103, e36948. [Google Scholar] [CrossRef] [PubMed]
- Raina, R.; Gondhi, N.K.; Gupta, A. Automated segmentation of acute leukemia using blood and bone marrow smear images: A systematic review. Multimed. Tools Appl. 2024, 1–34. [Google Scholar] [CrossRef]
- Andreevna, K.M.; Vyacheslavovna, K.E.; Valeryevna, G.S.; Gunai Nariman, M.; Igorevich, L.M.; Yegorovich, C.G.; Nikolaevich, K.A.; Nikolaevich, U.V.; Encarnacion Ramirez, M.D.J.; Montemurro, N. Long-Term Survival of a Child with Atypical Teratoid-Rhabdoid Tumor and Acute Lymphoblastic Leukemia: A Case Report. Surgeries 2024, 5, 184–193. [Google Scholar] [CrossRef]
- Valenti, V.E.; Kirizawa, J.M.; Garner, D.M.; Arab, C. Considerations about heart rate variability in leukemia. Support. Care Cancer 2020, 28, 421. [Google Scholar] [CrossRef]
- Turcotte, L.M.; Liu, Q.; Yasui, Y.; Arnold, M.A.; Hammond, S.; Howell, R.M.; Smith, S.A.; Weathers, R.E.; Henderson, T.O.; Gibson, T.M. Temporal trends in treatment and subsequent neoplasm risk among 5-year survivors of childhood cancer, 1970–2015. Jama 2017, 317, 814–824. [Google Scholar] [CrossRef] [PubMed]
- Jiwani, N.; Gupta, K.; Pau, G.; Alibakhshikenari, M. Pattern recognition of acute lymphoblastic Leukemia (ALL) using computational deep learning. IEEE Access 2023, 11, 29541–29553. [Google Scholar] [CrossRef]
- Anilkumar, K.; Manoj, V.; Sagi, T. A review on computer aided detection and classification of leukemia. Multimed. Tools Appl. 2024, 83, 17961–17981. [Google Scholar] [CrossRef]
- Das, P.K.; Diya, V.; Meher, S.; Panda, R.; Abraham, A. A systematic review on recent advancements in deep and machine learning based detection and classification of acute lymphoblastic leukemia. IEEE Access 2022, 10, 81741–81763. [Google Scholar] [CrossRef]
- Zhou, M.; Wu, K.; Yu, L.; Xu, M.; Yang, J.; Shen, Q.; Liu, B.; Shi, L.; Wu, S.; Dong, B. Development and evaluation of a leukemia diagnosis system using deep learning in real clinical scenarios. Front. Pediatr. 2021, 616. [Google Scholar] [CrossRef] [PubMed]
- Khandekar, R.; Shastry, P.; Jaishankar, S.; Faust, O.; Sampathila, N. Automated blast cell detection for Acute Lymphoblastic Leukemia diagnosis. Biomed. Signal Process. Control 2021, 68, 102690. [Google Scholar] [CrossRef]
- Chola, C.; Muaad, A.Y.; Bin Heyat, M.B.; Benifa, J.B.; Naji, W.R.; Hemachandran, K.; Mahmoud, N.F.; Samee, N.A.; Al-Antari, M.A.; Kadah, Y.M. BCNet: A Deep Learning Computer-Aided Diagnosis Framework for Human Peripheral Blood Cell Identification. Diagnostics 2022, 12, 2815. [Google Scholar] [CrossRef] [PubMed]
- Bhute, A.; Bhute, H.; Pande, S.; Dhumane, A.; Chiwhane, S.; Wankhade, S. Acute Lymphoblastic Leukemia Detection and Classification Using an Ensemble of Classifiers and Pre-Trained Convolutional Neural Networks. Int. J. Intell. Syst. Appl. Eng. 2024, 12, 571–580. [Google Scholar]
- Rastogi, P.; Khanna, K.; Singh, V. LeuFeatx: Deep learning–based feature extractor for the diagnosis of acute leukemia from microscopic images of peripheral blood smear. Comput. Biol. Med. 2022, 142, 105236. [Google Scholar] [CrossRef] [PubMed]
- Dese, K.; Raj, H.; Ayana, G.; Yemane, T.; Adissu, W.; Krishnamoorthy, J.; Kwa, T. Accurate Machine-Learning Based classification of Leukemia from Blood Smear Images. Clin. Lymphoma Myeloma Leuk. 2022, 21, e903–e914. [Google Scholar] [CrossRef] [PubMed]
- Ansari, S.; Navin, A.H.; Babazadeh Sangar, A.; Vaez Gharamaleki, J.; Danishvar, S. Acute Leukemia Diagnosis Based on Images of Lymphocytes and Monocytes Using Type-II Fuzzy Deep Network. Electronics 2023, 12, 1116. [Google Scholar] [CrossRef]
- Abhishek, A.; Jha, R.K.; Sinha, R.; Jha, K. Automated detection and classification of leukemia on a subject-independent test dataset using deep transfer learning supported by Grad-CAM visualization. Biomed. Signal Process. Control 2023, 83, 104722. [Google Scholar] [CrossRef]
- Salimans, T.; Goodfellow, I.; Zaremba, W.; Cheung, V.; Radford, A.; Chen, X. Improved techniques for training gans. Adv. Neural Inf. Process. Syst. 2016, 29, 1023. [Google Scholar]
- Goodfellow, I.; Pouget-Abadie, J.; Mirza, M.; Xu, B.; Warde-Farley, D.; Ozair, S.; Courville, A.; Bengio, Y. Generative adversarial networks. Commun. ACM 2020, 63, 139–144. [Google Scholar] [CrossRef]
- Kiani, S.; Salmanpour, A.; Hamzeh, M.; Kebriaei, H. Learning Robust Model Predictive Control for Voltage Control of Islanded Microgrid. IEEE Trans. Autom. Sci. Eng. 2024, 10, 10–15. [Google Scholar] [CrossRef]
- Seifi, N.; Al-Mamun, A. Optimizing Memory Access Efficiency in CUDA Kernel via Data Layout Technique. J. Comput. Commun. 2024, 12, 124–139. [Google Scholar] [CrossRef]
- Salehi, F.; Pariafsai, F.; Dixit, M.K. The impact of misaligned idiotropic and visual axes on spatial ability under altered visuospatial conditions. Virtual Real. 2023, 27, 3633–3647. [Google Scholar] [CrossRef]
- Salehi, F.; Pariafsai, F.; Dixit, M.K. How Human Spatial Ability Is Affected by the Misalignment of Idiotropic and Visual Axes. In Proceedings of the International Conference on Human-Computer Interaction, Washington, DC, USA, 29 June–4 July 2024; Springer: Cham, Switzerland, 2023; pp. 169–186. [Google Scholar]
- Salehi, F.; Pariafsai, F.; Dixit, M.K. The Impact of Different Levels of Spatial Cues on Size Perception: A Spatial Perception Study of Altered Conditions. In Proceedings of the International Conference on Human-Computer Interaction, Washington, DC, USA, 29 June–4 July 2024; Springer: Cham, Switzerland, 2024; pp. 74–85. [Google Scholar]
- Salehi, F.; Razavi, M.; Smith, M.; Dixit, M. Integrated Eye-Tracking and EEG Data Collection and Synchronization for Virtual Reality-Based Spatial Ability Assessments. Intell. Hum. Syst. Integr. (IHSI 2024) 2024, 119, 348–360. [Google Scholar] [CrossRef]
- Chen, Y.; Zhang, D.; Zhu, K.; Yan, R. An adaptive activation transfer learning approach for fault diagnosis. IEEE/ASME Trans. Mechatron. 2023, 28, 2645–2656. [Google Scholar] [CrossRef]
- Iscioglu, E.; Bahrami, S. Graphical user interface and graphic design and layout of ATUTOR LCMS. In Proceedings of the ICERI2012 Proceedings, IATED: 2012, Madrid, Spain, 19–21 November 2012; pp. 3121–3127. [Google Scholar]
- Bahrami, S. Conceptual graphic design and interaction design of learning management system ATutor. Indian J. Sci. Technol. 2015, 14, 263–269. [Google Scholar] [CrossRef]
- Kiaghadi, M.; Sheikholeslami, M.; Alinia, A.; Boora, F.M. Predicting the performance of a photovoltaic unit via machine learning methods in the existence of finned thermal storage unit. J. Energy Storage 2024, 90, 111766. [Google Scholar] [CrossRef]
- Kiaghadi, M.; Hoseinpour, P. University admission process: A prescriptive analytics approach. Artif. Intell. Rev. 2023, 56, 233–256. [Google Scholar] [CrossRef]
- Mohammadabadi, S.M.S.; Zawad, S.; Yan, F.; Yang, L. Speed Up Federated Learning in Heterogeneous Environment: A Dynamic Tiering Approach. arXiv 2023, arXiv:2312.05642. [Google Scholar]
- Mohammadabadi, S.M.S.; Liu, Y.; Canafe, A.; Yang, L. Towards Distributed Learning of PMU Data: A Federated Learning based Event Classification Approach. In Proceedings of the 2023 IEEE Power & Energy Society General Meeting (PESGM), Orlando, FL, USA, 16–20 July 2023; pp. 1–5. [Google Scholar]
- EskandariNasab, M.; Raeisi, Z.; Lashaki, R.A.; Najafi, H. A GRU–CNN model for auditory attention detection using microstate and recurrence quantification analysis. Sci. Rep. 2024, 14, 8861. [Google Scholar] [CrossRef] [PubMed]
- Ardabili, S.Z.; Bahmani, S.; Lahijan, L.Z.; Khaleghi, N.; Sheykhivand, S.; Danishvar, S. A novel approach for automatic detection of driver fatigue using EEG signals based on graph convolutional networks. Sensors 2024, 24, 364. [Google Scholar] [CrossRef] [PubMed]
- Peng, H.; Ran, R.; Luo, Y.; Zhao, J.; Huang, S.; Thorat, K.; Geng, T.; Wang, C.; Xu, X.; Wen, W. Lingcn: Structural linearized graph convolutional network for homomorphically encrypted inference. Adv. Neural Inf. Process. Syst. 2024, 36, 103–111. [Google Scholar]
- Demircioğlu, A. The effect of feature normalization methods in radiomics. Insights Into Imaging 2024, 15, 2. [Google Scholar] [CrossRef] [PubMed]
- He, F.; Mahmud, M.P.; Kouzani, A.Z.; Anwar, A.; Jiang, F.; Ling, S.H. An improved SLIC algorithm for segmentation of microscopic cell images. Biomed. Signal Process. Control 2022, 73, 103464. [Google Scholar] [CrossRef]
- Khaleghi, N.; Hashemi, S.; Peivandi, M.; Ardabili, S.Z.; Behjati, M.; Sheykhivand, S.; Danishvar, S. EEG-based functional connectivity analysis of brain abnormalities: A review study. Inform. Med. Unlocked 2024, 47, 101476. [Google Scholar] [CrossRef]
- Diaa, U. A Deep Learning Model to Inspect Image Forgery on SURF Keypoints of SLIC Segmented Regions. Eng. Technol. Appl. Sci. Res. 2024, 14, 12549–12555. [Google Scholar] [CrossRef]
- Khaleghi, N.; Hashemi, S.; Ardabili, S.Z.; Sheykhivand, S.; Danishvar, S. Salient Arithmetic Data Extraction from Brain Activity via an Improved Deep Network. Sensors 2023, 23, 9351. [Google Scholar] [CrossRef]
- Al-Bashir, A.K.; Khnouf, R.E.; Bany Issa, L.R. Leukemia classification using different CNN-based algorithms-comparative study. Neural Comput. Appl. 2024, 36, 9313–9328. [Google Scholar] [CrossRef]
- Awais, M.; Ahmad, R.; Kausar, N.; Alzahrani, A.I.; Alalwan, N.; Masood, A. ALL classification using neural ensemble and memetic deep feature optimization. Front. Artif. Intell. 2024, 7, 1351942. [Google Scholar] [CrossRef]
- Milani, O.H.; Atici, S.F.; Allareddy, V.; Ramachandran, V.; Ansari, R.; Cetin, A.E.; Elnagar, M.H. A fully automated classification of third molar development stages using deep learning. Sci. Rep. 2024, 14, 13082. [Google Scholar] [CrossRef] [PubMed]
- Milani, O.H.; Nguyen, T.; Parekh, A.; Cetin, A.E.; Prasad, B. 0537 incident hypertension prediction in obstructive sleep apnea using machine learning. Sleep 2023, 46 (Suppl. 1), A236–A237. [Google Scholar] [CrossRef]

| Layer | Shape of Weight Tensor | Shape of Bias | Number of Parameters |
|---|---|---|---|
| Graph Conv1 | (P1, 32, 32) | 32 | 1024 × P1 + 32 |
| Batch Norm | (32) | 32 | 64 |
| Graph Conv2 | (P2, 32, 32) | 32 | 1024 × P2 + 32 |
| Batch Norm | (32) | 32 | 64 |
| Graph Conv3 | (P3, 32, 32) | 32 | 1024 × P3 + 32 |
| Batch Norm | (32) | 32 | 64 |
| Graph Conv4 | (P4, 32, 32) | 32 | 1024 × P4 + 32 |
| Batch Norm | (32) | 32 | 64 |
| Graph Conv5 | (P5, 32, 32) | 32 | 1024 × P5 + 32 |
| Batch Norm | (32) | 32 | 64 |
| Graph Conv6 | (P6, 32, 2) | 2 | 64 × P6 + 32 |
| Batch Norm | (16) | 16 | 32 |
| Softmax | - | 2 | 2 × A × P6 |
| Parameters | Values | Optimal Value |
|---|---|---|
| Batch Size in GAN | 4, 6, 8, 10, 12 | 12 |
| Optimizer in GAN | Adam, SGD, Adamax | Adamax |
| Number of CNN Layers | 3, 4, 5, 6 | 6 |
| Learning Rate in GAN | 0.1, 0.01, 0.001, 0.0001 | 0.001 |
| Number of Graph Conv Layers | 2, 3, 4, 5, 6, 7 | 6 |
| Batch Size in GCN | 8, 16, 32 | 32 |
| Batch normalization | Relu, Leaky-Relu | Relu |
| Learning Rate in GCN | 0.1, 0.01, 0.001, 0.0001, 0.00001 | 0.0001 |
| Dropout Rate | 0.1, 0.2, 0.3 | 0.2 |
| Weight of optimizer | ||
| Error function | MSE, Cross Entropy | Cross Entropy |
| Optimizer in GCN | Adam, SGD, Adadelta, Adamax | SGD |
| Regions | 50 | 100 | 150 | 200 |
| Accuracy | 94.1% | 99.4% | 91% | 82% |
| Measurement Index | Performance (%) |
|---|---|
| Accuracy | 99.4 |
| Sensitivity | 99.2 |
| Precision | 98.1 |
| Specificity | 97.3 |
| Kappa coefficient | 0.85 |
| Ref. | Dataset | Classification | Methods | Accuracy |
|---|---|---|---|---|
| Zhou et al. [12] | ALL-IDB1 | ALL | FCNN | 85% |
| Khandkar et al. [13] | ALL-IDB1 and CNMC 2019 | ALL, AML | Thresholding | 95% |
| Chola et al. [14] | HPBC | Leukemia types | BCNet | 98.51% |
| Bhute et al. [15] | Private dataset | Leukemia | Pre-trained networks (VGG16, Resnet60, Inception V3) | 90% |
| Rastogi et al. [16] | ALL-IDB2 | ALL-AML | Leufeatx | 96.15% |
| Dese et al. [17] | Private dataset | Leukemia types | Deep learning methods | 95% |
| Ansari et al. [18] | Private dataset | ALL-AML | Type 2 fuzzy + CNN | 98% |
| Abhishek et al. [19] | Private dataset | Leukemia types | VGG 16 | 85% |
| Areen et al. [43] | ALL-IDB | Leukemia types | Pre-trained networks (VGG16, Resnet60, Inception V3) | 94% |
| Awais et al. [44] | Private dataset | ALL | CNNs | 99.15% |
| Proposed method | New dataset (ALL + AML) | ALL-AML | Graph theory + CNN | 99.4% |
Disclaimer/Publisher’s Note: The statements, opinions and data contained in all publications are solely those of the individual author(s) and contributor(s) and not of MDPI and/or the editor(s). MDPI and/or the editor(s) disclaim responsibility for any injury to people or property resulting from any ideas, methods, instructions or products referred to in the content. |
© 2024 by the authors. Licensee MDPI, Basel, Switzerland. This article is an open access article distributed under the terms and conditions of the Creative Commons Attribution (CC BY) license (https://creativecommons.org/licenses/by/4.0/).
Share and Cite
Zare, L.; Rahmani, M.; Khaleghi, N.; Sheykhivand, S.; Danishvar, S. Automatic Detection of Acute Leukemia (ALL and AML) Utilizing Customized Deep Graph Convolutional Neural Networks. Bioengineering 2024, 11, 644. https://doi.org/10.3390/bioengineering11070644
Zare L, Rahmani M, Khaleghi N, Sheykhivand S, Danishvar S. Automatic Detection of Acute Leukemia (ALL and AML) Utilizing Customized Deep Graph Convolutional Neural Networks. Bioengineering. 2024; 11(7):644. https://doi.org/10.3390/bioengineering11070644
Chicago/Turabian StyleZare, Lida, Mahsan Rahmani, Nastaran Khaleghi, Sobhan Sheykhivand, and Sebelan Danishvar. 2024. "Automatic Detection of Acute Leukemia (ALL and AML) Utilizing Customized Deep Graph Convolutional Neural Networks" Bioengineering 11, no. 7: 644. https://doi.org/10.3390/bioengineering11070644
APA StyleZare, L., Rahmani, M., Khaleghi, N., Sheykhivand, S., & Danishvar, S. (2024). Automatic Detection of Acute Leukemia (ALL and AML) Utilizing Customized Deep Graph Convolutional Neural Networks. Bioengineering, 11(7), 644. https://doi.org/10.3390/bioengineering11070644

